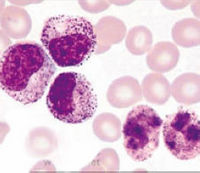

类白血病反应
| A+医学百科 >> 类白血病反应 |
类白血病反应(leukemoid reaction)是指患者在某些情况下出现外周血白细胞显著增高(>50×109/L)和(或)存在有异常未成熟白细胞,与某些白血病相类似,但随后病程或尸检证实没有白血病。类白血病反应是正常骨髓对某些刺激信号作出的一种反应。类白血病反应并不与幼粒幼红细胞增多症同义,后者是指外周血中有幼稚粒细胞和有核红细胞,而不考虑白细胞总数。
目录 |
流行病学
类白血病反应的流行病学调查报道很少。原岛三郎等分析了国立东京第一医院连续3年类白血病反应的发生率,分别占住院患者的0.28%、0.39%和0.90%,占门诊病人的0.04%、0.05%和0.12%。
病因
类白血病反应的发生常与各种感染、中毒、恶性肿瘤变态反应性疾病甚至急性失血、溶血性贫血、组织损伤等有关。 1.感染是最常见的原因。常见病原体有细菌、螺旋体、原虫、病毒等。感染引
起的类白血病反应,分为以下几类:
(1)粒细胞型类白血病反应:常见于肺炎、脑膜炎、白喉、结核病(主要为粟粒性结核、浸润性结核溶解播散期肺外结核)等重症传染病。
(2)淋巴细胞型类白血病反应:常见于百日咳、水痘、传染性单核细胞增多症、传染性淋巴细胞增多症、结核病等。
(3)单核细胞型类白血病反应:常见于结核病、巨细胞病毒感染、亚急性细菌性心内膜炎等。
(4)嗜酸性粒细胞型类白血病反应:常见于寄生虫感染,如血吸虫病、丝虫病、疟疾、棘球蚴病(包虫病)等。
2.恶性肿瘤多见于晚期患者肺和胃肠道恶性肿瘤,尤其是转移到肝骨髓后易发生类白血病反应。多发性骨髓瘤、霍奇金病、黑色素瘤骨肉瘤、乳腺癌、绒毛膜上皮癌引起类白血病反应亦见报道。肿瘤引起的类白血病反应多属粒细胞型亦有类似红白血病淋巴细胞型较少见并常伴有贫血和血小板减少。
3.中毒
(2)药物性:如砷剂、解热镇痛药、磺胺药、肾上腺素糖皮质激素、锂盐等。还有报道:用大剂量阿糖胞苷治疗急性白血病缓解期引起健康搜索的类白血病反应。
(3)其他:子痫、一氧化碳中毒四氯乙烷中毒、尿毒症、酮症酸中毒、食物中毒等。
5.急性组织损伤常见于外伤性组织创伤(如颅脑外伤、挤压综合征)、大面积烧伤此外还可见于肺梗死心肌梗死、电休克等。
6.其他疾病变态反应性疾病(如剥脱性皮炎过敏性肺炎)、高热中毒、电离辐射性疾病脾切除术后、妊娠晚期等健康搜索。
发病机制
外周血白细胞增高或出现幼稚细胞,是细胞产生或释放的异常,可能伴有清除、破坏的缺陷,其具体机制不一致,目前主要的几种观点如下: 1.细胞调控机制改变造血细胞的增生、分化受多种细胞生长因子的调节,这些因子在类白血病反应中起着重要作用。
微生物或内毒素进入机体健康搜索,被巨噬细胞吞噬后,宿主防御系统迅速做出反应巨噬细胞和T细胞被激活,产生各种造血生长因子,如G-CSF,GM-CSF,M-CSF,并可释放细
胞因子、淋巴因子(如IL-1,IL-3,TNF等)。lL-1IL-3鶒TNF及细菌产物又可刺激GM-CSF和G-CSF等鶒的分泌鶒。CM-CSF健康搜索,G-CSFIL-3等可刺激骨髓造血干细胞和前体细胞的增生、分化,促使贮存池中的中性粒细胞大量释放至边缘池、循环池,使外周血白细胞计数明显增高,同时亦可出现一些早幼粒、原粒等幼稚细胞,呈现白血病样的变化。当微生物被包裹或清除后,刺激集落刺激因子(CSF)基因表达鶒的因素被清除鶒,外周血白细胞计数又可恢复正常健康搜索。
嗜酸性粒细胞的调控与中性粒细胞相似。许多因素如抗原抗体反应、外源蛋白寄生虫等均可引起嗜酸性粒细胞增多,通过嗜酸性粒细胞释放因子、可刺激嗜酸性粒细胞产生的易扩散因子、来源于致敏T细胞的嗜酸性粒细胞集落刺激因子和可刺激嗜酸性粒细胞产生的低相对分子质量多肽等促进嗜酸性粒细胞的增生释放目前研究较多鶒的是致敏T细胞亚群,它合成细胞因子(如IL-5),刺激嗜酸性粒细胞的增生、分化,并鶒在短期内释放至循环池中出现白血病样的改变。嗜酸性粒细胞的释放足有选择的,很少出现幼稚嗜酸性粒细胞。
另外,某些肿瘤细胞也可产生集落刺激因子刺激造血细胞的增生、分化、释放鶒毒素、缺氧免疫反应、化学物质等因素可损伤骨髓毛细血管内皮细胞使髓血屏障受损导致部分幼稚细胞进入血循环,出现类白血病反应。脾切除后,可能因为骨髓失去了部分凋控作用,因而当某些外因刺激骨髓时,更易于将幼粒或幼红细胞释放至外周血内鶒。
2.髓外造血骨髓纤维化症、癌症晚期及慢性严重贫血均可出现肝脾等处的髓外造血灶,外周血中可出现中性幼粒细胞及有核红细胞。
3.血细胞的再分布传染性淋巴细胞增多症传染性单核细胞增多症时外周血淋巴细胞明显增多,还可出现幼淋巴细胞,可能与淋巴细胞重新分布有关。百日咳患者的百日咳杆菌可产生一种抑制淋巴细胞由血液向组织转移的因子,致淋巴细胞在血液中停留时间过长,数量增多。此时血中的淋巴细胞以辅助性T细胞为主。另外在一些感染恢复期患者,由于组织中需要的中性粒细胞减少,致中性粒细胞在外周血中积聚,出现类似白血病的反应。
临床表现
可见于各年龄组,但儿童较为多见,男女发生率无区别临床表现主要是原发病的症状和体征发热较常见,可有肝、脾、淋巴结肿大及皮肤淤斑等出血症状在一76例系列中脾大发生率为20.0%,在另一50例系列中脾大发生率为22.0%,但一般仅只有轻度肿大健康搜索。
最常见的并发症为继发感染、发热、肝脾、淋巴结肿大、贫血、溶血性贫血
诊断
类白血病反应的诊断应综合考虑以下几点:
1.有明确的病因如感染中毒、恶性肿瘤等。
2.原发病治愈或好转后,类白血病反应可迅速消失。
4.根据白细胞计数和分类情况各型类白血病反应诊断标准如下:①粒细胞型类白血病反应,白细胞计数>50×109/L,或外周血白细胞计数<50×109/L,但出现原粒、幼粒细胞,成熟中性粒细胞胞质中常出现中毒性颗粒和空泡碱性磷酸酶积分明显增高。骨髓象除了有粒细胞增生和左移现象外,没有白血病细胞的形态异常;②淋巴细胞型类白血病反应,白细胞数明显增多健康搜索,超过50×109/L其中40%以上为淋巴细胞;若白细胞<50×109/L,其中异形淋巴细胞应>20%健康搜索,并出现幼淋巴细胞;③单核细胞型类白血病反应白细胞>30×l09/L,单核细胞>30%;若白细胞<30×109/L,幼单核细胞应>5%;④嗜酸粒细胞型类白血病反应外周血嗜酸性粒细胞明显增加但无幼稚嗜酸粒细胞;骨髓中原始细胞比例不增高,嗜酸性粒细胞形态无异常;⑤红白血病型类白血病反应,外周血白细胞及有核红细胞总数>50×109/L并有幼稚粒细胞;若白细胞总数<50×109/L,原粒细胞应>2%。骨髓中除粒细胞系增生外,尚有红细胞系增生;⑥浆细胞型类白血病反应,白细胞总数增多或不增多,外周血浆细胞>2%。
LR是一种并发症或是一种中间病理过程主要表现在血液学异常,故临床病史及体征无法提供任何诊断线索。血象检查是诊断的关键骨髓检查的主要意义在于排除白血病。原发病存在以及原发病缓解好转后血象随之恢复正常是最主要的诊断依据尤其是类急性白血病反应,在某时间段内几乎无法与急性白血病区分,随诊动态观察为惟一的鉴别手段。
鉴别诊断
1.尽管类白反应的血液学改变多种多样,大多数病例诊断并不困难;但对有淋巴结肿大、脾大、发热或出血的患者与白血病的区别较困难,有些病例只有在尸解时才能确诊。
检查
1.血象两个较大系列报道血红蛋白平均值分别为116g/L、124g/L,白细胞平均值分别22.7×109/L、28.0×109/L,血小板计数平均值分别为274×109/L、275×109/L。类白血病反应患者血红蛋白和血小板计数一般正常,白细胞计数一般鶒在(50~100)×109/L。在结核病引起的类白血病反应患者有白细胞高达220×109/L的报道。白细胞分类可见少量幼稚细胞,但以较近成熟阶段细胞为主,原粒细胞很少>15%,无Auer小体。有75%的细胞为中幼粒细胞和晚幼粒细胞以及嗜碱粒细胞高达15%的报道。类白血病反应常伴有原始红细胞血症(erythroblastemia)中性粒细胞常有中毒颗粒,有时还有Döhle小体。
2.骨髓造血细胞增生活跃,粒系可有核左移但原始粒细胞极少超过20%鶒,一般无Auer小体,但也偶见于结核病类白血病反应红系和巨核系一般正常。癌骨髓转移类白血病反应还可见数量不等的癌细胞。
3.其他外周血中性粒细胞碱性磷酸酶正常或升高,四氮唑蓝染色在感染性类白血病反应时显著增高。
其它辅助检查
2.B超肝脾、淋巴结肿大
3.骨髓组织病理特点窦状血管正常或轻度增多常有假戈谢细胞,肥大细胞易见含铁颗粒巨噬细胞可显著增多,脂肪细胞分布异常,大部分分布在骨小梁旁。
治疗
类白血病反应的治疗主要是针对原发病的治疗,如抗感染、治疗肿瘤控制溶血解毒等。同时还应加强支持、对症治疗,包括补充叶酸、维生素B12等造血原料;对严重贫血患者应及时输血;伴有弥散性血管内凝血健康搜索的患者还应积极纠正之鶒。
预后
类白血病反应预后一般较好健康搜索,去除或治疗原发病后类白血病反应可消失,预后主要由原发性疾病决定。
预防
1.尽可能减少感染,避免接触有害物质及药物。
2.防止一氧化碳中毒食物中毒。
3.对于子痫、尿毒症、急性失血、溶血急性组织创伤恶性肿瘤及时给予积极有效的治疗。
4.适时锻炼,增强体质提高自身的抗病能力。
参看
|
||||||||||||||||||||||||||||||||||||||||||||||||||||||
| 关于“类白血病反应”的留言: | |
|
目前暂无留言 | |
| 添加留言 | |